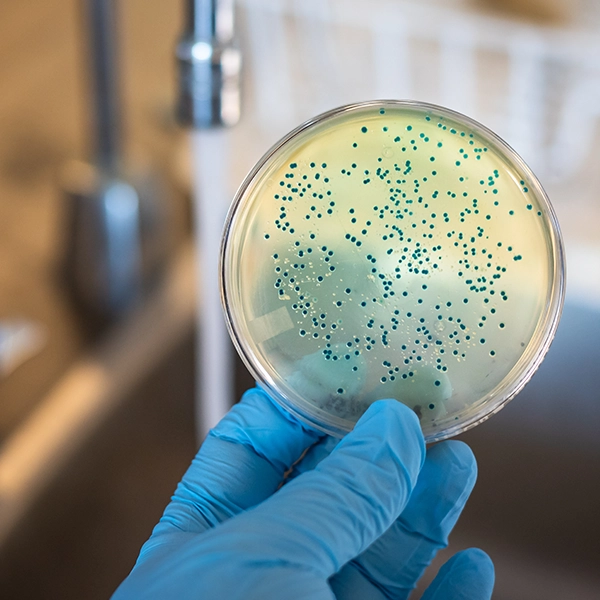

Our Solutions
Food safety isn’t one-size-fits-all, and neither are our solutions.
At ADP-SA, we offer a comprehensive range of testing and monitoring systems designed to help you maintain compliance, improve efficiency, and reduce risk across your operations. From rapid hygiene checks to advanced pathogen detection, our solutions are built to deliver accurate results, streamline workflows, and give you confidence in every stage of your process.

Hygiene Monitoring

Keep your environment clean, compliant, and audit-ready. Our hygiene monitoring systems use ATP testing and rapid protein detection to verify cleaning effectiveness in real time.
Key Solutions
- ATP Hygiene Monitoring Systems
- Surface Protein Testing
- Cleaning Validation Tools
Benefits
- Immediate Results
- Easy to Use
- Improves Cleaning Standards
- Supports HACCP Compliance
Microbial Testing
Fast, reliable microbial detection without the lab drama. From Petrifilm plates to automated systems, we help you streamline testing and reduce turnaround time.
Key Solutions
- Petrifilm Plates (ready-to-use, no prep required)
- Soleris Rapid Testing System
Benefits
- Faster Results (as little as 14–18 hours)
- Reduced Lab Workload
- Consistent, Reliable Outcomes
Pathogen Detection

Accurate detection when it matters most. We offer advanced molecular and culture-based solutions to identify harmful pathogens quickly and confidently.
Key Solutions
- Molecular Detection Systems (LAMP technology)
- One Broth One Plate (OBOP) Workflows
- Rapid Lateral Flow Tests
Benefits
- High Sensitivity and Specificity
- Next-Day or Faster Results
- Easy-To-Use Workflows
Allergen Testing

Protect your customers and your brand. Our allergen testing solutions detect even trace levels of allergens across surfaces and products.
Key Solutions
- Rapid Lateral Flow Allergen Tests
- ELISA Quantitative Testing Kits
- Cleaning Validation Tools
Detects
- Milk, egg, gluten, soy, peanut, tree nuts, and more
Natural Toxins Testing

Stay compliant with accurate toxin detection. We provide both rapid and quantitative testing solutions for mycotoxins and other contaminants.
Key Solutions
- Reveal Q+ Rapid Tests
- ELISA Toxin Testing Kits
Benefits
- Fast, Actionable Results
- High Accuracy
- Easy On-Site Testing
Sample Preparation

Better samples = better results. Simple as that. We supply high-quality sampling tools designed for efficiency, consistency, and reliability.
Includes
- Swabs and Sponges
- Sample Bags
- Prepared Media
- Collection Kits
These tools ensure consistent testing and reduce risk across your food safety program.
Get In Touch Now
Upgrade Food Safety
We help you identify risks early, streamline your testing processes, and ensure your products meet the highest safety standards — without unnecessary complexity.
Whether you need routine testing, specialised analysis, or a fully integrated solution, we’ll tailor an approach that fits your operation and scales with your business.
TECHNOLOGY HIGHLIGHTS
Precision Tools Powering Your Lab
These technologies are designed to streamline workflows, improve accuracy, and deliver reliable results across your operations. From rapid microbial detection to real-time hygiene monitoring, each solution supports smarter, more efficient testing.

Petrifilm Plates
Ready-to-use microbial testing plates that eliminate prep time and simplify workflows.
- No agar preparation
- Compact and efficient
- Reliable and proven results

Soleris Rapid Testing System
Next-generation microbial detection using optical technology.
- Faster results
- Reduced costs
- Improved efficiency
- Non-destructive testing

Clean-Trace Hygiene System
ATP-based hygiene monitoring system for real-time cleaning verification.
- Results in under 30 seconds
- Tracks trends and compliance
- Easy integration into workflows

AccuPoint Advanced NG
Complete sanitation monitoring system with smart data tracking.
- Fast pass/fail results
- RFID-enabled tracking
- Advanced reporting software
TECHNOLOGY HIGHLIGHTS
Precision Tools Powering Your Lab
These technologies are designed to streamline workflows, improve accuracy, and deliver reliable results across your operations. From rapid microbial detection to real-time hygiene monitoring, each solution supports smarter, more efficient testing.

Petrifilm Plates
Ready-to-use microbial testing plates that eliminate prep time and simplify workflows.
- No agar preparation
- Compact and efficient
- Reliable and proven results

Soleris Rapid Testing System
Next-generation microbial detection using optical technology.
- Faster results
- Reduced costs
- Improved efficiency
- Non-destructive testing

Clean-Trace Hygiene System
ATP-based hygiene monitoring system for real-time cleaning verification.
- Results in under 30 seconds
- Tracks trends and compliance
- Easy integration into workflows

AccuPoint Advanced NG
Complete sanitation monitoring system with smart data tracking.
- Fast pass/fail results
- RFID-enabled tracking
- Advanced reporting software